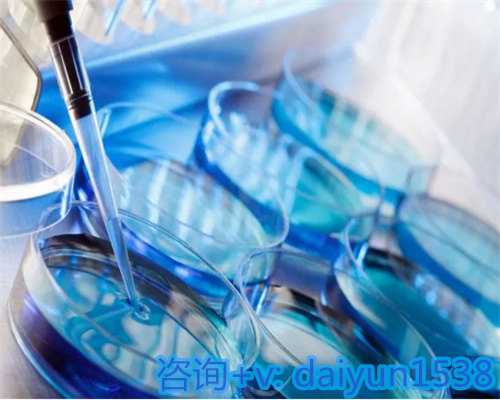
温州供卵机构哪家正规,为你打造最舒适的代怀生子环境

一、浙江代怀孕陈倩芸
浙江代怀孕陈倩芸:代孕争议与代孕合法化思考
近年来,代孕作为一项备受关注的议题,引起了广泛的讨论。在浙江省,代孕作为一种合法的选择,已经得到了一定的法律支持和保护。但是,与此同时,代孕也存在着一系列的争议和问题,需要深入思考。
首先,代孕作为一种交易,涉及到伦理、法律和道德等多个方面的问题。代孕服务通常由第三方机构提供,这意味着孩子不是亲生父母的孩子,而是由另外的人控制的。这样的关系可能会引发一系列的问题,比如代孕母亲是否有权利保护自己的孩子、孩子是否应该有自己的权利和自由等等。此外,代孕服务的费用通常非常高昂,这也引发了一些人的争议和质疑。
其次,代孕合法化是否合适?在许多国家,代孕是非法的,因为它涉及到许多法律问题,比如孩子的生物学身份、代孕母亲的人权等等。然而,在一些国家,代孕是合法的,比如荷兰、比利时和加拿大等,这也引发了一些争议。一些人认为,代孕应该受到限制和监管,以确保孩子的生物学身份和代孕母亲的人权得到保护。另一些人则认为,代孕应该合法化,以促进社会经济发展,并为那些无法自然怀孕的人提供一种选择。
最后,代孕合法化后需要解决的问题还有很多。比如,代孕机构需要得到严格的监管和认证,以确保它们的合法性和服务质量。此外,代孕母亲需要获得必要的培训和支持,以确保她们能够胜任这项任务。最后,代孕服务的费用也需要得到合理的控制和解释,以确保人们能够承担这项费用。
浙江代怀孕陈倩芸:代孕作为一项备受关注的议题,涉及到伦理、法律和道德等多个方面的问题。在浙江省,代孕作为一种合法的选择,已经得到了一定的法律支持和保护,但代孕也存在着一系列的争议和问题,需要深入思考。合法化代孕需要解决许多问题,包括伦理、法律、道德、经济、服务和监管等方面的问题。
二、浙江省人民医院试管供卵代生中心
浙江省人民医院试管供卵代生中心是一家综合性医疗机构,提供试管婴儿技术服务。该中心拥有一支技术精湛、经验丰富的医疗团队,采用先进的技术设备和治疗方案,为患者提供全方位的医疗服务。同时,该中心还建立了完善的质量控制体系,保障患者治疗过程的安全和质量。
三、浙江二胎准生证怎么办理
1、凭结婚证、男女双方身份证,到户口所在地计划生育部门领取申请表。
2、填好申请表,到所在村(居委会)签署意见。
3、到计划生育服务部门孕检,如怀孕,先流产。
4、凭申请表、计划生育服务部门的孕检证明和夫妻两人合影(办理二孩的全家三人合影),到户口所在地计划生育办公室办理。
当事人需要在妊娠前向单位提出申请,再由单位向所辖办事处计生办提出申请。申请时同时提交具备规定可以生育第二个子女的证明,夫妻双方居民身份证、户口本、结婚证。再婚的须提交离婚证书等相关证明材料、双方所在单位或村(居)民委员会出具的本人生育情况证明等。对符合生育条件的申请人,相关部门应在30日内给予发放生育证。
综上所述就是关于“浙江二胎准生证办理流程”的相关介绍,现在我国已经放开二胎政策,目前政策也比较灵活,也不要求办节育手续,提倡自由避孕。夫妻生育二胎,也需要办理准生证,一般在怀孕后三个月内办好,这个证很重要,是合法生育的凭证,当然要注意证的有效期,证件过去就失效。